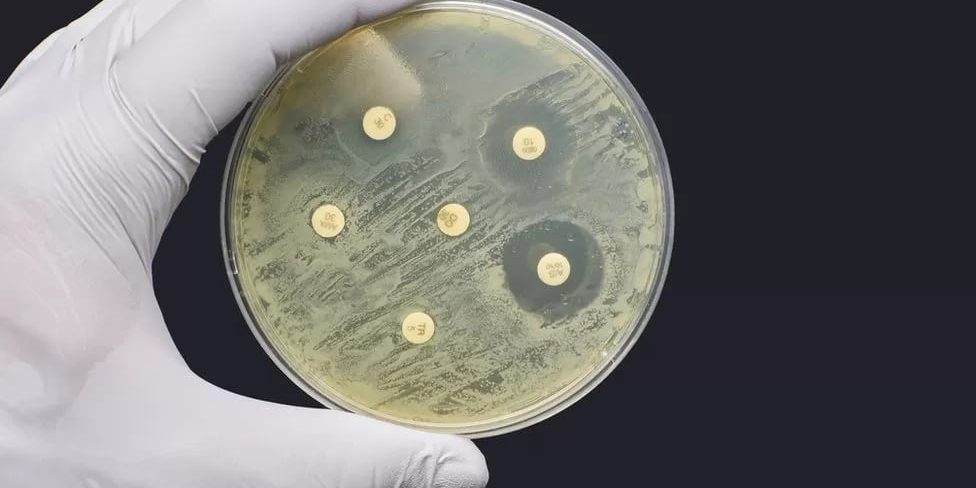

Introduction:
Bacteria does not have a membrane-bound nucleus and other internal structures (Kara Rogers, 2020), which it, therefore, classifies as a prokaryotic cell. Bacteria reproduce in 2 different ways, binary fission and conjugation. Binary fission is an asexual reproduction method that only involves 1 parent cell and the genes from the parent cell gets passed down to the offspring. These genes in the offspring are identical to the parent cell (Mcgraw Hill, 2001), which results in an exact clone. Conjugation is a sexual reproduction method where 2 parents give rise to the offspring (the offspring gets half the genes from each parent cell)(Mcgraw Hill, 2001), and each offspring will vary genetically from their siblings and parents .
When there is bacteria that needs to be killed, using disinfectants is something that helps rapidly kill them. However, sometimes bacterial resistance can occur when the bacteria changes in ways which render the use of antimicrobial agents (Douglas Morier, 2021), such as antibiotics/antiseptics being used to cure these infections. In this lab it is comparing antibiotics and antiseptics to see which can kill the bacteria more effectively. To determine this we need to carefully look at the zone of inhibition which will show us which of the 2 are more effective.
Hypothesis:
If antiseptic agents are used to kill bacteria, then it will be more effective in the process of killing bacteria than antibiotic agents, as seen by the size of the diameters of the antiseptics and antibiotics tested.
Materials:
Table 1: Materials And Apperatices For Lab (In Millimetres)
| Materials | Apperatices |
| 10 mm Of Household Bleach | 3 116mm Sized Petri Dishes With Nutrient Agar |
| 10 mm Of Sterile Paper | Incubator |
| 10 mm Of Household Disinfectant | 1 Ruler (mm) |
| 10 mm Of Penicillin | Computer With Internet Explorer Downloaded |
| 10 mm Of Amoxicillin | 3 116mm Sized Test Tubes |
| 10 mm Of Erythromycin | |
| 116mm Of Haemophilus Influenzae | |
| 116mm Of Staphylococcus | |
| 116mm Of Streptococcus Pneumoniae |
Reference: (Mcgraw Hill, 2016) (Mcgraw Hill, 2001)
Procedure:
- First, pull up internet explorer on the computer and open the Glencoe virtual lab.
- Start by placing all of the antibiotics and antiseptics on the petri dish (with the sterile paper in the center).
- Now, select the “Haemophilus Influenzae” bacteria and click on each of the items on the petri dish.
- Once all the bacteria has been placed on the antibiotics and antiseptics, then place the petri dish in the incubator for 24 hours (the time is sped up since performing lab on computer).
- Once the timer is up, take the petri dish out of the incubator and place it back down.
- Take the ruler and measure the diameter of the now killed bacteria and record it on an observation table as shown in Table 1.
- Repeat steps 2-6 for the “Staphylococcus bacteria”.
- Finally repeat steps 2-6 for the “Streptococcus Pneumoniae” bacteria. Reference: (Mcgraw Hill, 2016)
(Mcgraw Hill, 2001)
Table 2: The Measurements Of Efficiency In Killing Bacteria Between Antibiotics And Antiseptics
| Antibiotics & Antiseptics | Protection Against Haemophilus Influenzae In mm + Percentage | Protection Against Staphylococcus In mm + Percentage | Protection Against Streptococcus Pneumoniae Percentage In mm + Percentage |
| Antibacterial Soap | 17mm (14.65%) | 14mm (12.06%) | 15mm (12.93%) |
| Household Bleach | 31mm (26.72%) | 30mm (25.86%) | 29mm (25%) |
| Household Disinfectants | 21mm (18.10%) | 20mm (17.24%) | 22mm (18.96%) |
| Penicillin | 29mm (25%) | 5mm (4.31%) | 33mm (28.44%) |
| Amoxicillin | 27mm (23.27%) | 12mm (10.34%) | 35mm (30.17%) |
| Erythromycin | 16mm (13.79%) | 25mm (21.55%) | 14mm (12.06%) |
| Sterile Paper | 0mm (0%) | 0mm (0%) | 0mm (0%) |
Reference: (Mcgraw Hill, 2001)
Graph 1: Comparing The Accuracy In Killing Bacteria Between Antibiotics And Antiseptics

Observations:
In the first table of data “Table 2: The Measurements Of Efficiency In Killing Bacteria Between Antibiotics And Antiseptics”, it is noticeable that the antiseptic products “Household Disinfectants”, “Household Bleach”, and “Antibacterial Soap” have higher diameters than the antibiotics “Penicillin”, “Amoxicillin”, and “Erythromycin” meaning it appears that they are much more efficient in killing bacteria than any of the antibiotics used in the lab.
As seen in the second table of data “Table 3: The Efficiency In Killing Bacteria Between Antibiotics And Antiseptics”, it is shown in the data that Amoxicillin has the same percentage of efficiency in killing the specific bacteria “Staphylococcus” and the bacteria” Streptococcus Pneumoniae” at a low 10.34% which could possibly be explained by the fact that both bacteria fall under the same bacterial shape “Cocci” meaning that the two could share the same amount of weaknesses against that particular antibiotic due to firstly, their similar size and secondly, other possible factors.
Reference: (“Table 2: The Measurements Of Efficiency In Killing Bacteria Between Antibiotics And Antiseptics”, 2021)
Discussion:
Antiseptics are better at controlling bacterial growth. As seen in Table 2: comparing the accuracy in killing bacteria between antibiotics and antiseptics, the percentage efficiency is a lot higher overall for the antiseptics. Comparing this to the antibiotics, it is shown that the antibiotics seem to have an overall lower efficiency percentage. This proves that Antiseptics are a lot better at controlling bacterial growth.
Antibiotics are least effective at controlling bacterial growth. As seen in Table 2: comparing the accuracy in killing bacteria between antibiotics and antiseptics, the percentage efficiency is a lot lower overall for the antibiotics. Comparing this to the antiseptics, it is shown that the antiseptics seem to have an overall higher efficiency percentage. Antibiotics do kill bacteria but are not as effective towards other infections (Jill Tilton, 2017) whereas antiseptics have a wider variety of microorganisms that it can target .
Conclusion:
This lab explored the differences between antibiotics and antiseptics, and compared them to see which one is more/less effective in killing bacteria. In the hypothesis it is stated how the antiseptic would be more effective in killing the bacteria compared to the antibiotic, which was correct after looking at the observation table. As seen in “Table 2: comparing the accuracy in killing bacteria between antibiotics and antiseptics”, the antiseptics had a higher diameter compared to the antibiotics, which seemed to have a much lower diameter. Very minimal errors occurred during this lab so the only main one was not being able to get the exact measurements due to looking at the lab off of the teachers computer rather than our own.
Reference: (“Table 2: comparing the accuracy in killing bacteria between antibiotics and antiseptics”, 2021)
Works Cited:
References
Hill, M. (Ed.). (2001). Nelson Biology 11 (1st ed.). Nelson Canada.
Hill, M. (2016, n.d n.d). Virtual Lab: What Kills Germs? glenco. Retrieved september 15, 2021, from http://www.glencoe.com/sites/common_assets/science/virtual_labs/LS08/LS08.
Rogers, K. (2020, december 4). Britannica. Bacteria. Retrieved september 15, 2021, from
https://www.britannica.com/science/bacteria
Schreiber, B. A. (2021, march 5). Britannica. Antibiotic Resistance. Retrieved September 15, 2021, from
https://www.britannica.com/science/antibiotic-resistance/additional-info#history
tilton, J. (2017, may 24). What Is The Difference Between Antiseptic And Antibiotic? Safetech of america. Retrieved September 2017, 2021, from https://safetec.com/blog/first-aid/what-is-the-difference-between-antiseptic-and-antibiotic/